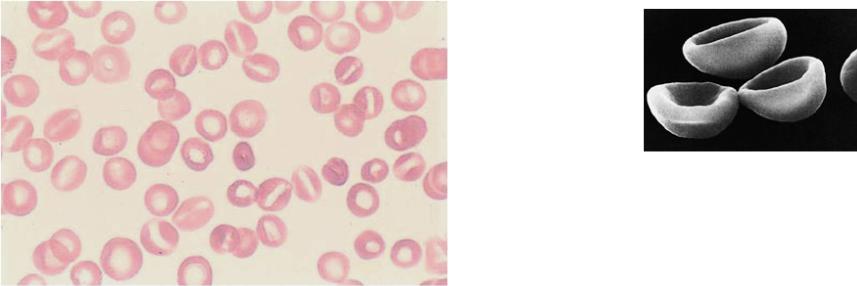
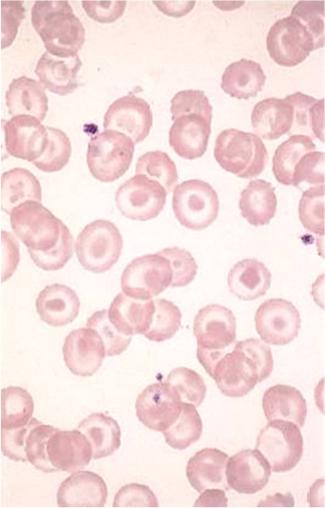
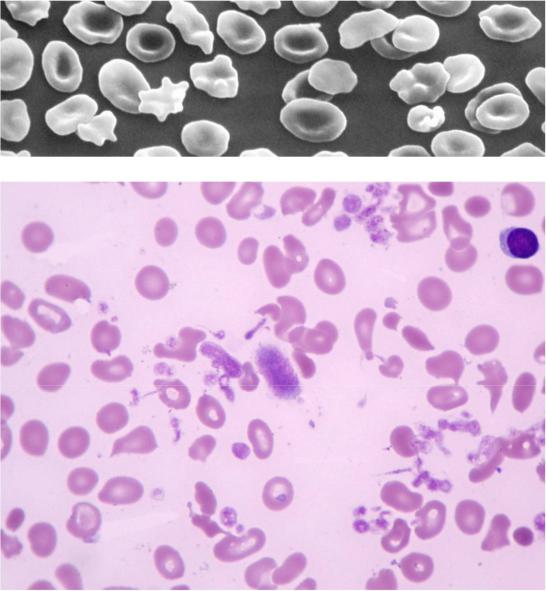

Материал: клинический+анализ+крови+2
Изменения размера и формы эритроцитов
Наследственный стоматоцитоз
•близок к микросфероцитозу.Имеется нарушение в структуре белков мембраны эритроцита.Эритроцитыв окрашенном мазке напоминают рыбий рот,откуда и произошло название патологии
•Гемолиз можетбыть полностью компенсированным за счёт усиления эритропоэза
Мазок
крови
Стоматоциты при электронной микроскопии

Изменения размера и формы эритроцитов
Серповидноклеточная анемия
•наблюдается при наследственной аномалии гемоглобина – появление гемоглобина S
•чаще встречается в странах с большой распространенностью малярии
Серповидные эритроциты видны в нативном препарате крови под покровным стеклом. Серповидность лучше выявляется при гипоксемии, когда перед забором крови из пальца на основание пальца накладывают нетугой жгутик из кольца резины, после чего делают прокол кожи мякоти пальца.
-талассемия
•Для талассемии характерно наличие в мазкахкрови мишеневидных эритроцитов
•Мишеневидные эритроциты имеют большую площадь мембраны, поэтому их максимальная осмотическая стойкостьрезко увеличена
•Содержание гемоглобина в эритроцитах уменьшено (гипохромия), объём их уменьшен (микроцитоз)

ОРЭ при талассемии
При талассемии эритроциты имеют небольшой объём при большой площади мембраны. При взгляде сверху у эритроцита в центре просветления видно более ярко окрашенное пятно, что делает их похожими на мишень.
В гипотонических растворах понижающейся концентрации объём их медленно возрастает за счёт поступления воды. Некоторые эритроциты выдерживают гипотонию до концентрации 0,2% NaCl, т.е. у них очень высокая максимальная резистентность
0,7%NaCl |
Концентрация раствора |
0,2%NaCl |
Изменения размера и формы эритроцитов
Смешанный
пойкилоцитоз наблюдается при различных тяжелых анемиях, в т.ч. у пациентов с некоторымиХМПЗ, и при миелодиспластическом синдроме